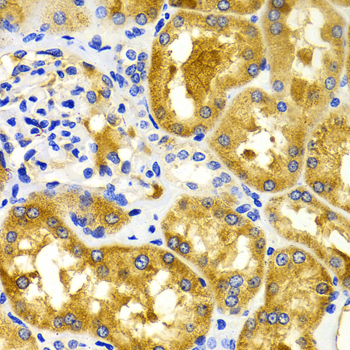

-
Product Name
CDK20 Polyclonal Antibody
- Documents
-
Description
Polyclonal antibody to CDK20
-
Tested applications
IHC
-
Species reactivity
Human, Rat
-
Alternative names
CDK20 antibody; CCRK antibody; CDCH antibody; P42 antibody; PNQALRE antibody; cyclin-dependent kinase 20 antibody
-
Isotype
Rabbit IgG
-
Preparation
Antigen: A synthetic peptide of human CDK20
-
Clonality
Polyclonal
-
Formulation
PBS with 0.02% sodium azide, 50% glycerol, pH7.3.
-
Storage instructions
Store at -20℃. Avoid freeze / thaw cycles.
-
Applications
IHC 1:50 - 1:100
-
Validations

Immunohistochemistry - CDK20 Polyclonal Antibody
Immunohistochemistry of paraffin-embedded rat spleen using CDK20 antibody at dilution of 1:200 (40x lens).
Immunohistochemistry - CDK20 Polyclonal Antibody
Immunohistochemistry of paraffin-embedded human kidney using CDK20 antibody at dilution of 1:100 (40x lens).

Immunohistochemistry - CDK20 Polyclonal Antibody
Immunohistochemistry of paraffin-embedded human liver cancer using CDK20 antibody at dilution of 1:100 (40x lens).
-
Background
Required for high-level Shh responses in the developing neural tube. Together with TBC1D32, controls the structure of the primary cilium by coordinating assembly of the ciliary membrane and axoneme, allowing GLI2 to be properly activated in response to SHH signaling (By similarity). Involved in cell growth. Activates CDK2, a kinase involved in the control of the cell cycle, by phosphorylating residue 'Thr-160'.
Related Products / Services
Please note: All products are "FOR RESEARCH USE ONLY AND ARE NOT INTENDED FOR DIAGNOSTIC OR THERAPEUTIC USE"
